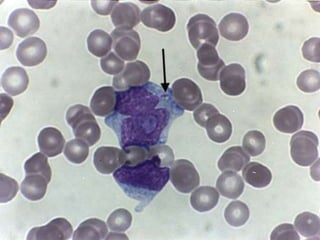
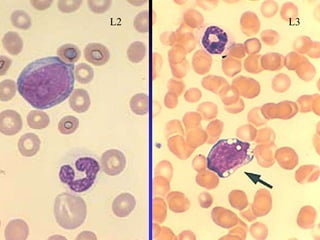
L3
L2
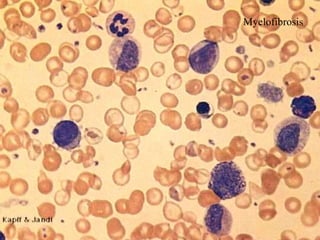
Myelofibrosis
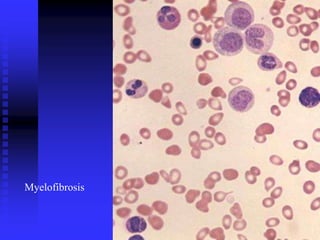
Myelofibrosis
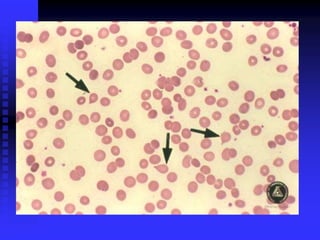
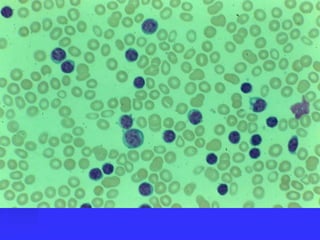
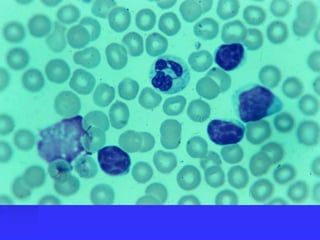

This document discusses various types of leukemia, including acute myeloid leukemia (AML), acute lymphoblastic leukemia (ALL), chronic myeloid leukemia (CML), and chronic lymphocytic leukemia (CLL). It covers classification systems for leukemia such as the French-American-British (FAB) and World Health Organization (WHO) classifications. Key diagnostic tests are outlined including cytochemical staining reactions, immunophenotyping using cell surface markers, cytogenetics including karyotyping, and molecular testing. Signs, symptoms and laboratory findings for different types of leukemia are also summarized.